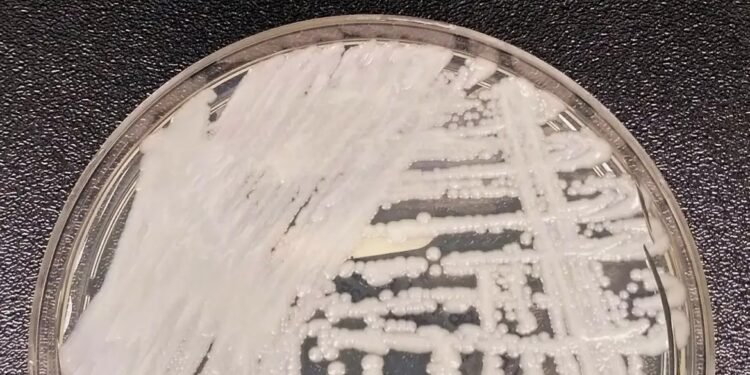
Fungo resistente avança nos hospitais da Europa e preocupa autoridades de saúde

GIRO MUNDO – A Agência Brasil anunciou que um fungo resistente a medicamentos, identificado como Candidozyma auris (anteriormente conhecido como Candida auris), que está se propagando rapidamente nos hospitais da Europa, segundo alerta divulgado esta semana pelo Centro Europeu de Prevenção e Controlo das Doenças (ECDC). A situação tem gerado preocupação entre autoridades de saúde pública e profissionais do setor hospitalar.
De acordo com o ECDC, entre 2013 e 2023 foram registados mais de 4.000 casos do fungo na União Europeia e países vizinhos, com um aumento significativo nos últimos anos. Em 2023, o patógeno foi detectado em 18 países da região.
O C. auris é conhecido por ser altamente resistente aos antifúngicos normalmente utilizados no tratamento, e propaga-se com facilidade em ambientes hospitalares, afetando especialmente pacientes com doenças pré-existentes ou internados por longos períodos.
Países mais afetados
Os maiores números de casos acumulados foram registados em Espanha, Grécia, Itália, Roménia e Alemanha. Já os surtos mais recentes foram relatados por Chipre, França e Alemanha.
O ECDC reforça que o controle do fungo exige medidas rigorosas de prevenção e vigilância nos hospitais, incluindo a identificação rápida de casos, isolamento de pacientes infectados e desinfeção adequada de ambientes.
“As infeções podem ser graves e, em alguns casos, fatais, especialmente entre os pacientes já debilitados”, destaca o relatório.
O crescimento da resistência do fungo aos tratamentos convencionais e a sua rápida disseminação acendem um alerta para o fortalecimento de políticas de controle de infeções nas instituições de saúde em toda a Europa.